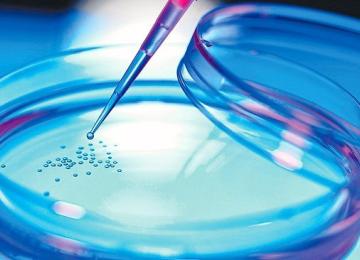

A screening system that alerts people and medical practitioners of a patient’s diabetes status has been launched in all cities across the country, said Ali Akbar Sayyari, deputy health minister.…
People
- People
Over the past three years, a total of 2.5 million units of blood plasma have been sent to Germany and Switzerland for production of plasma-derived medicines, said the director general of Iran…
PeopleIn a meeting between chancellor of Tehran’s Amirkabir University of Science and Technology, Amir Golru, and chancellor of Hong Kong University Leung Chun-ying on Sunday, the two sides discussed…
PeopleGermany and Switzerland reported new outbreaks of a severe strain of bird flu on Saturday in the latest in a series of cases across Europe.
The H5N8 virus has also been found in Austria,…
PeopleThe number of women addicts has doubled since the last decade according to reports by several domestic news agencies.
However, Abbas Deilamizadeh, a social pathologist, believes the figure…
PeopleWomen have never had it easy when it comes to entrepreneurship in Iran. Despite the measures taken and efforts made, they still face numerous challenges.
PeopleAnnually, 8 million people are admitted to hospitals and their average length of stay is 2.7 days, said Deputy Health Minister Iraj Harirchi on Sunday.
PeopleAbout 100 cases of stem cell transplants in the country each year are received from matching but unrelated donors, said head of the Iran Blood Transfusion Organization. “Around 8,000 patients are…
PeopleThe USERN Prize was conferred for the first time on five awardees at the 1st International Congress of Universal Scientific Education and Research Network (USERN) held November 8-10 at Tehran…
PeopleThe Health Ministry has advised all Iranian pilgrims visiting the holy city of Karbala in Iraq for the Arba’een mourning rituals to get vaccinated against the flu.
PeopleA South Korean investment company (GG Trading and Contracting Company) has signed an agreement with the Health Ministry to build an international neuroscience hospital in east Tehran (District 4…
PeopleOne luxury tour company in the US is promoting a new trip to Iran, describing it as the first opportunity to see an Iran opening up to the West after last year’s nuclear deal.
PeopleTourism potentials and investment opportunities of the Iranian province of Kurdestan were introduced to a Japanese delegation on Saturday, during a meeting with local tourism and cultural heritage…
PeopleTourism, overcrowding and sky-high living costs are pushing out residents from the city of Venice in Italy.
The population dropped below 55,000 this month, compared to about 78,000 in 1990…
PeopleTurkey warned its citizens about traveling to the United States on Saturday in response to what the foreign ministry called increasingly violent protests against president-elect Donald Trump.
PeopleTo increase the number of Iran's inbound tourists from five million to 12 million in the next five years, $13 per tourist need to be spent on advertising and marketing, while the current figure is…
PeopleKerman Province's top tourism office has declared that construction of lodging facilities, particularly ecolodges, in the south of the province will face no problems in obtaining construction…
PeopleThere are currently 10 traditional medicine faculties at universities of medical sciences across the country, said Mahmoud Khodadoust, deputy health minister for traditional medicine. “Twenty more…
PeopleAn estimated 600,000 Iranians suffer from Alzheimer’s, says Dr. Masoumeh Salehi, head of the Iran Alzheimer’s Association.
Given that there are about 23 million families in the country, it…
PeopleObesity and overweight among Iranians often make headlines, with some news outlets calling the country one of the most obese, and others voicing concern over the future of the stout population.
PeopleSmartphones may be hurting sleep quality, a new study revealed.
Billions of people around the world use smartphones, and it is safe to say that more than half of them use phones in bed…
PeopleAll physically challenged people will be issued an international ID card by mid 2017, according to the head of the State Welfare Organization.
PeopleOn the occasion of International Street Vendors Day (observed globally on November 14), a specialized seminar will be held in Tehran on November 13 at Tehran University’s Social Sciences Campus.…
PeopleThe rate of antibiotic abuse is unfortunately high in the country, said Dr Rasoul Dinarvand, head of the Food and Drug Administration (FDA). “Antibiotic misuse can make medicines ineffective…
PeopleA campaign aimed to raise public awareness on diabetes, its causes, and treatment was launched at Tehran’s Friday Prayers by a number of artists and well known artistic figures in the country on…
People